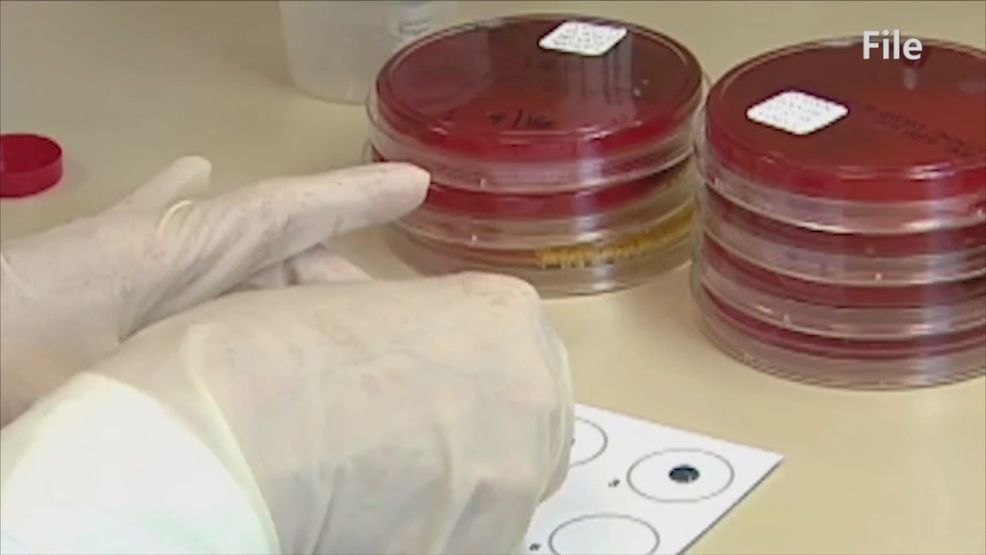
A healthcare worker testing items for bacteria in a lab. (FILE)

There’s a superbug that’s emerging in many hospital systems across the country.
It’s a fungus known as Candida auris, or C. auris.
“It is resistant to many of the most common antifungal agents that we use and is responsible for a lot of outbreaks in health care systems,” said Dr. Kevin Gibas, the associate medical director of infection control at Brown University Health’s Rhode Island Hospital.
Dr. Kevin Gibas, the associate medical director of infection control at Brown University Health’s Rhode Island Hospital spoke with NBC 10’s Barbara Morse about the emerging superbug fungus. (WJAR)
“It’s one fungus that’s very tricky to treat but it’s also very tricky to manage in health care systems because it’s not only resistant to the most common anti fungal agents to treat it in humans, but it’s also resistant to a lot of the most common cleaning agents that we use in hospital systems,” Gibas said.
That’s one reason for its rapid spread.
“It can live on our bodies and often we may not know about it,” explained he said.
It is spread through person to person contact, and can also live on surfaces so if an infected person is treated at a health care facility, it can be unknowingly passed on to someone with a weaker immune system, through an infected breathing tube or catheter.
“It can cause wound infections, it can cause infections in the blood,” said Gibas. “Once it takes hold in the health care system it’s really hard to eradicate.”
Rhode Island Hospital was put to the test with a singular case last year–the first and so far, only, in the state.
That patient had been transferred from an out-of-state hospital with high rates– they were screened and isolated immediately.
“When we have a case like this we have to think differently how we sterilize things, how we clean the room. There’s a lot of thought that goes into how we do this.”
A healthcare worker testing items for bacteria in a lab. (FILE)
Screening typically involves swabbing the armpit.
States with widespread Candida Auris infections include Florida, Illinois, New York, Nevada and California.
Those most susceptible to this severe illness because of it are older adults and those with compromised immune systems.